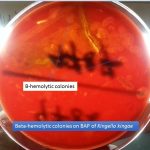
Kingella kingae on blood agar
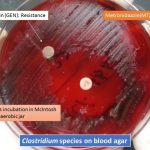
Clostridium on blood agar

Collection Group: Clinical Bacteriology
MIU Test for Bacteria: Introduction,Test procedure and Result Interpretation
 Introduction of MIU Test MIU test stands for motility indole...
Introduction of MIU Test MIU test stands for motility indole...
Kingella: Growth on Blood Agar, Introduction, Pathogenecity, Laboratory Diagnosis and Treatment
Kingella kingae on blood agar Kingella kingae on blood agar...
Kingella kingae on blood agar Kingella kingae on blood agar...
Clostridium on Blood Agar: Introduction, Pathogenecity, Laboratory Diagnosis and Treatment
Introduction of Clostridium Clostridium species on blood agar as shown...
Introduction of Clostridium Clostridium species on blood agar as shown...
